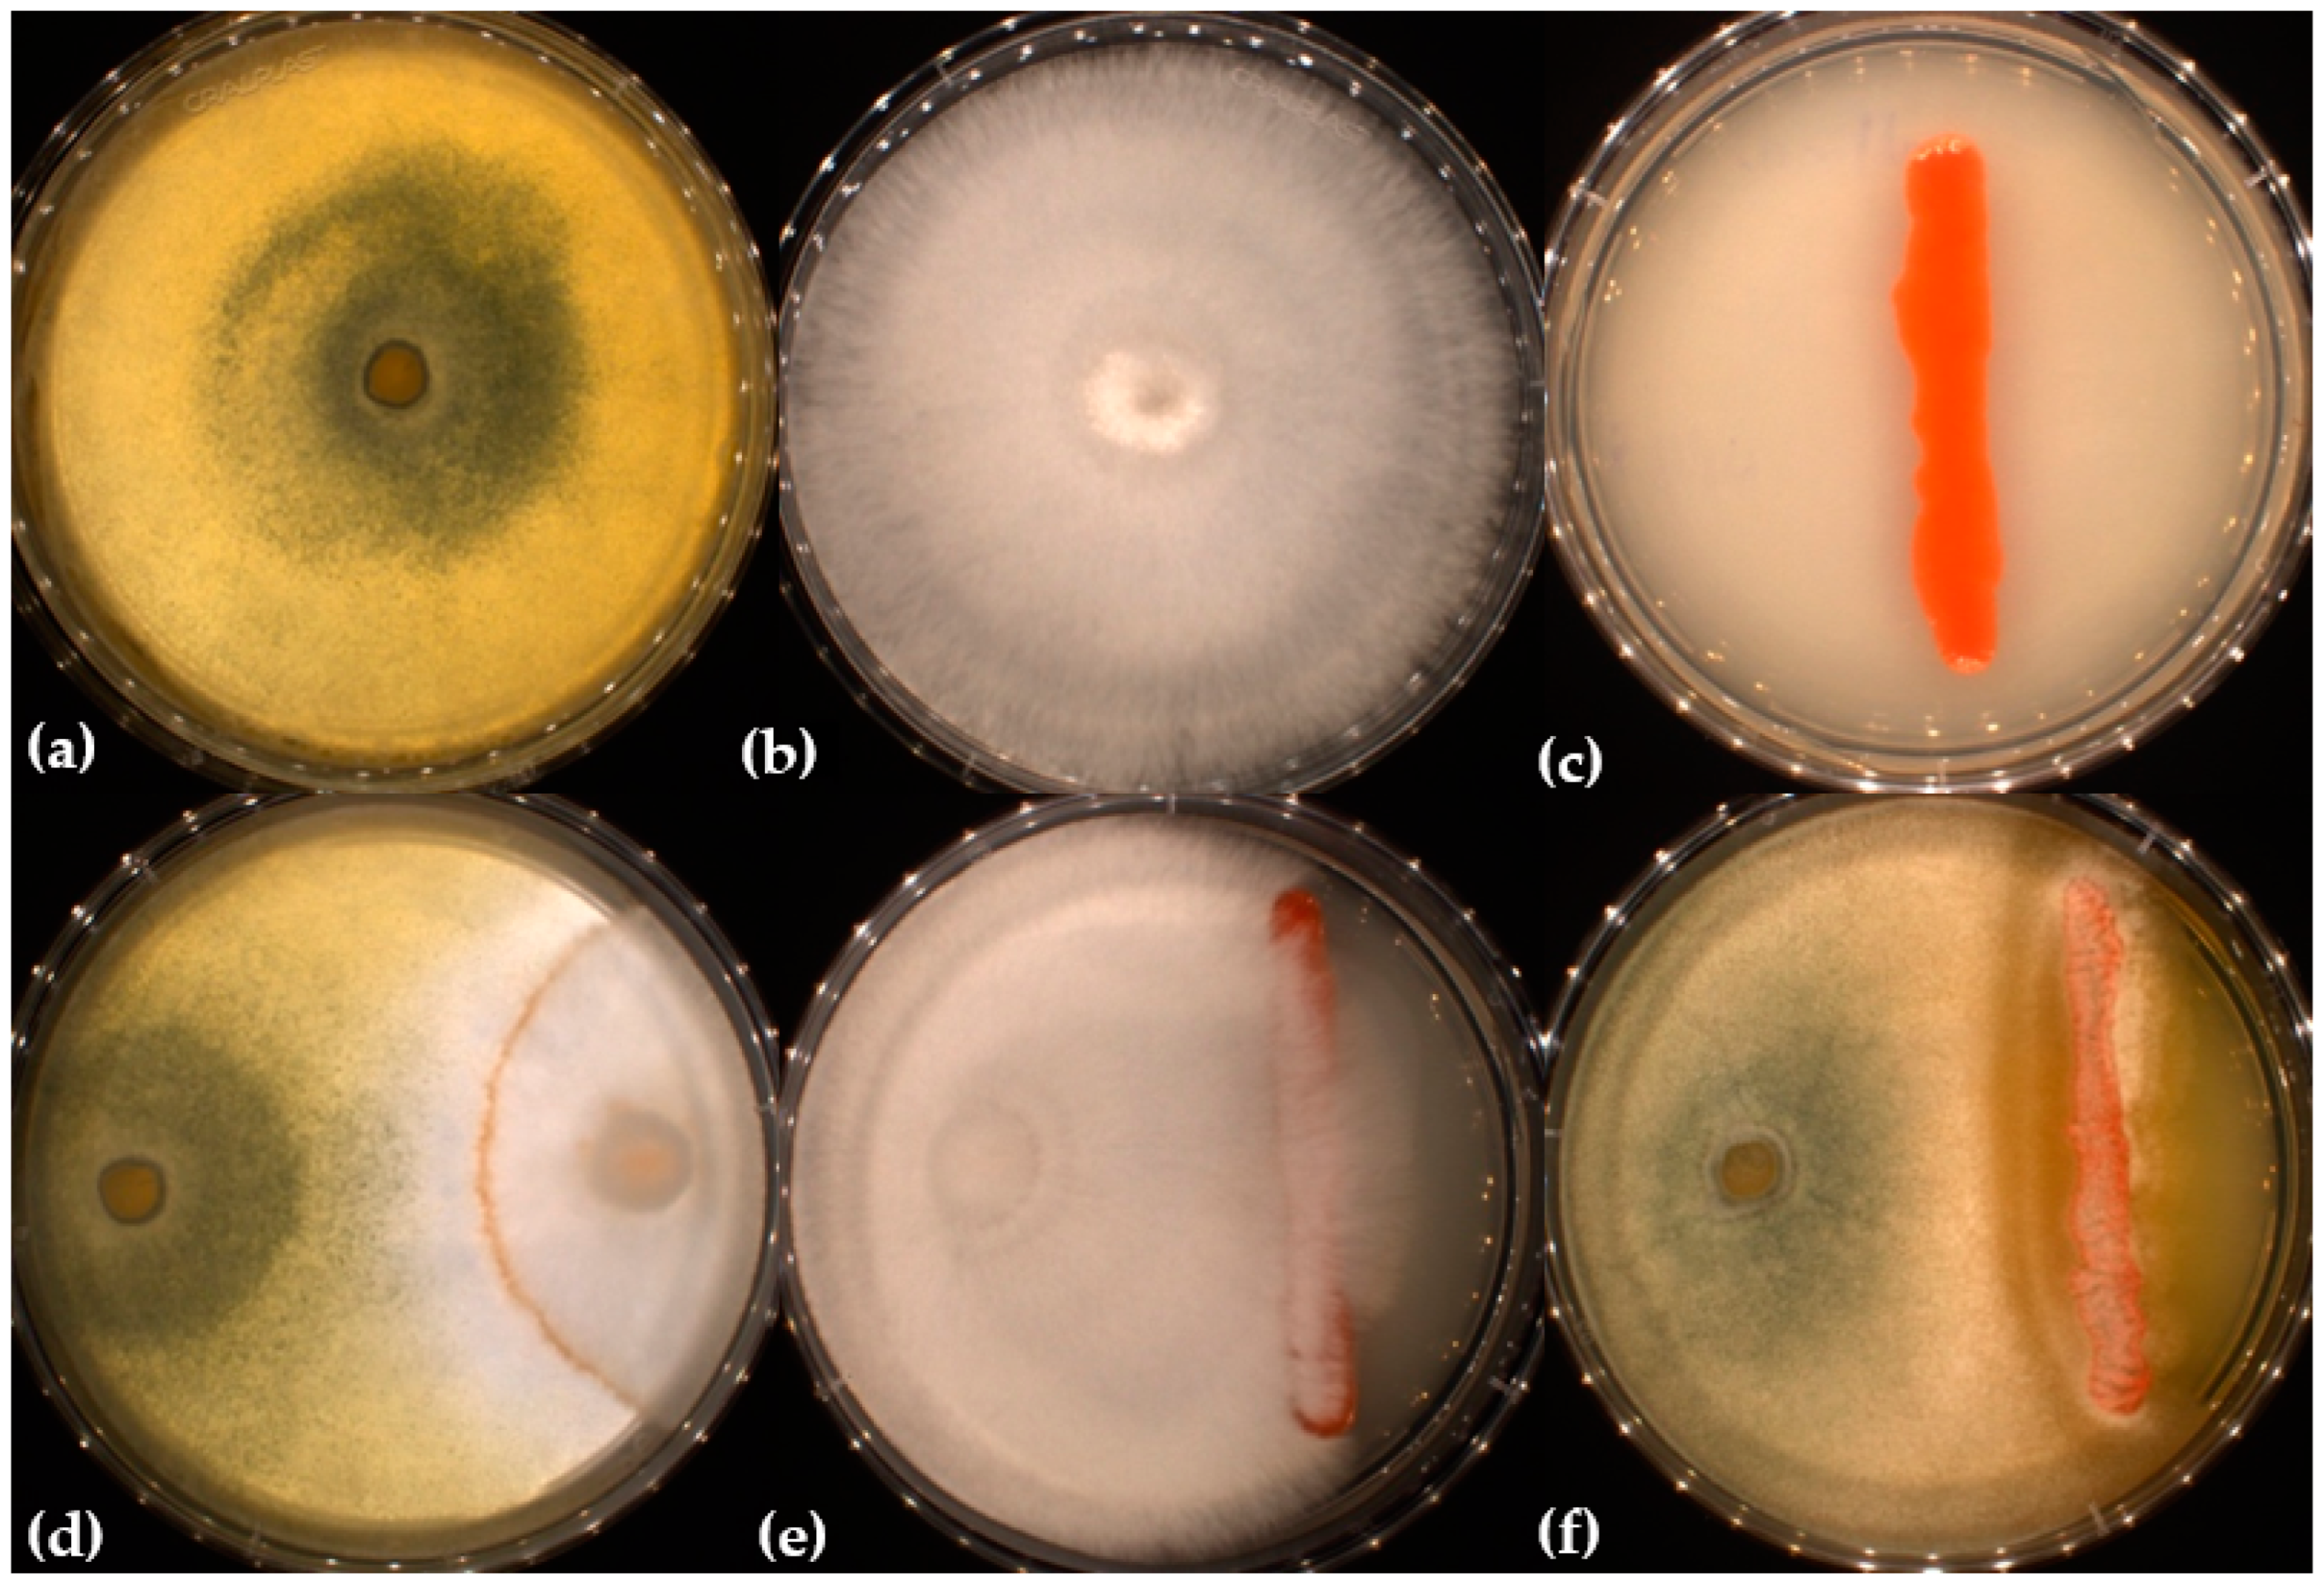
Fermentation 09 00945 g001

Improvement of Laccase Activity in Co-Culture of Panus lecomtei and Sporidiobolus pararoseus and Its Application as an Enzymatic Additive in Biomass Hydrolysis and Dye Decolorization
Abstract
:1. Introduction
2. Materials and Methods
2.1. Fungi Strains and Biomass
2.2. Production of Enzymatic Extracts of Mono or Co-Cultures of P. lecomtei, T. reesei and S. pararoseus
2.2.1. Mono or Co-Cultures of Panus lecomtei and Trichoderma reesei
2.2.2. Co-Culture of Panus lecomtei and Sporidiobolus pararoseus
2.2.3. Co-Culture of Panus lecomtei, Trichoderma reesei and Sporidiobolus pararoseus
2.3. Selection of S. pararoseus Inoculum Time Interval and Volume in Co-Culture with P. lecomtei on Laccase Production
2.4. Enzymatic Assays
2.5. Hydrolysis of Pretreated Sugarcane Bagasse by the Co-Cultures Enzymatic Cocktails
2.6. Decolorization of Dye Remazol Brilliant Blue R with Enzyme Extracts
2.7. Statistical Analysis
3. Results
3.1. Growth Interaction of S. pararoseus with T. reesei and P. lecomtei
3.2. Effect of Inoculum Time Interval and Volume of S. pararoseus in Co-Culture with P. lecomtei on Laccase Production
3.3. Enzymatic Activities of Mono and Co-Cultures Extracts
3.4. Hydrolytic Performance of Co-Cultures Enzymatic Cocktails
3.5. Effect of Enzyme Extracts in the Decolorization of the Dye Remazol Brilliant Blue R
4. Discussion
5. Conclusions
Author Contributions
Funding
Institutional Review Board Statement
Informed Consent Statement
Data Availability Statement
Acknowledgments
Conflicts of Interest
References
- Sista Kameshwar, A.K.; Qin, W. Comparative Study of Genome-Wide Plant Biomass-Degrading CAZymes in White Rot, Brown Rot and Soft Rot Fungi. Mycology 2018, 9, 93–105. [Google Scholar] [CrossRef] [PubMed]
- Ardila-Leal, L.D.; Poutou-Piñales, R.A.; Pedroza-Rodríguez, A.M.; Quevedo-Hidalgo, B.E. A Brief History of Colour, the Environmental Impact of Synthetic Dyes and Removal by Using Laccases. Molecules 2021, 26, 3813. [Google Scholar] [CrossRef]
- Gupta, V.K.; Kubicek, C.P.; Berrin, J.-G.; Wilson, D.W.; Couturier, M.; Berlin, A.; Filho, E.X.F.; Ezeji, T. Fungal Enzymes for Bio-Products from Sustainable and Waste Biomass. Trends Biochem. Sci. 2016, 41, 633–645. [Google Scholar] [CrossRef] [PubMed]
- Hiscox, J.; O’Leary, J.; Boddy, L. Fungus Wars: Basidiomycete Battles in Wood Decay. Stud. Mycol. 2018, 89, 117–124. [Google Scholar] [CrossRef] [PubMed]
- Peláez, R.D.R.; Wischral, D.; Cunha, J.R.B.; Mendes, T.D.; Pacheco, T.F.; de Siqueira, F.G.; Almeida, J.R.M. de Production of Enzymatic Extract with High Cellulolytic and Oxidative Activities by Co-Culture of Trichoderma reesei and Panus lecomtei. Fermentation 2022, 8, 522. [Google Scholar] [CrossRef]
- Ijoma, G.N.; Selvarajan, R.; Tekere, M. The Potential of Fungal Co-Cultures as Biological Inducers for Increased Ligninolytic Enzymes on Agricultural Residues. Int. J. Environ. Sci. Technol. 2019, 16, 305–324. [Google Scholar] [CrossRef]
- Luo, F.; Zhong, Z.; Liu, L.; Igarashi, Y.; Xie, D.; Li, N. Metabolomic Differential Analysis of Interspecific Interactions among White Rot Fungi Trametes versicolor, Dichomitus squalens and Pleurotus ostreatus. Sci. Rep. 2017, 7, 5265. [Google Scholar] [CrossRef]
- Kot, A.M.; Kieliszek, M.; Piwowarek, K.; Błażejak, S.; Mussagy, C.U. Sporobolomyces and Sporidiobolus—Non-Conventional Yeasts for Use in Industries. Fungal Biol. Rev. 2021, 37, 41–58. [Google Scholar] [CrossRef]
- Zhang, J.; Ke, W.; Chen, H. Enhancing Laccase Production by White-Rot Fungus Trametes hirsuta SSM-3 in Co-Culture with Yeast Sporidiobolus pararoseus SSM-8. Prep. Biochem. Biotechnol. 2020, 50, 10–17. [Google Scholar] [CrossRef]
- Wang, H.; Peng, L.; Ding, Z.; Wu, J.; Shi, G. Stimulated Laccase Production of Pleurotus Ferulae JM301 Fungus by Rhodotorula mucilaginosa Yeast in Co-Culture. Process Biochem. 2015, 50, 901–905. [Google Scholar] [CrossRef]
- Guo, C.; Zhao, L.; Wang, F.; Lu, J.; Ding, Z.; Shi, G. β-Carotene from Yeasts Enhances Laccase Production of Pleurotus eryngii Var. ferulae in Co-Culture. Front. Microbiol. 2017, 8, 1101. [Google Scholar]
- Guimarães, M.B.; de Siqueira, F.G.; Campanha, R.B.; de Aquino Ribeiro, J.A.; Oliveira Magalhães, P.; Mendonça, S. Evaluation of Bio-Detoxification of Jatropha Curcas Seed Cake and Cottonseed Cake by Basidiomycetes: Nutritional and Antioxidant Effects. Waste Biomass Valor 2022, 13, 1475–1490. [Google Scholar] [CrossRef]
- Soares Neto, C.B.; Conceição, A.A.; Gomes, T.G.; de Aquino Ribeiro, J.A.; Campanha, R.B.; Barroso, P.A.V.; Machado, A.E.V.; Mendonça, S.; De Siqueira, F.G.; Miller, R.N.G. A Comparison of Physical, Chemical, Biological and Combined Treatments for Detoxification of Free Gossypol in Crushed Whole Cottonseed. Waste Biomass Valor 2021, 12, 3965–3975. [Google Scholar] [CrossRef]
- Ghose, T.K. Measurement of Cellulase Activities. Pure Appl. Chem. 1987, 59, 257–268. [Google Scholar] [CrossRef]
- Miller, G.L. Use of Dinitrosalicylic Acid Reagent for Determination of Reducing Sugar. Anal. Chem. 1959, 31, 426–428. [Google Scholar] [CrossRef]
- Wolfenden, B.S.; Willson, R.L. Radical-Cations as Reference Chromogens in Kinetic Studies of Ono-Electron Transfer Reactions: Pulse Radiolysis Studies of 2,2′-Azinobis-(3-Ethylbenzthiazoline-6-Sulphonate). J. Chem. Soc. Perkin Trans. 1982, 2, 805–812. [Google Scholar] [CrossRef]
- Heinzkill, M.; Bech, L.; Halkier, T.; Schneider, P.; Anke, T. Characterization of Laccases and Peroxidases from Wood-Rotting Fungi (Family Coprinaceae ). Appl. Environ. Microbiol. 1998, 64, 1601–1606. [Google Scholar] [CrossRef]
- Soni, S.K.; Batra, N.; Bansal, N.; Soni, R. Bioconversion of Sugarcane Bagasse into Second Generation Bioethanol after Enzymatic Hydrolysis with In-House Produced Cellulases from Aspergillus sp. S4B2F. BioRes 2010, 5, 741–757. [Google Scholar] [CrossRef]
- Sluiter, A.; Hames, B.; Ruiz, R.; Scarlata, C.; Sluiter, J.; Templeton, D.; Crocker, D.L.A.P. Determination of Structural Carbohydrates and Lignin in Biomass Determination of Structural Carbohydrates and Lignin in Biomass. Natl. Renew. Energy Lab. 2008, 2011, 1–9. [Google Scholar]
- Yadav, A.; Yadav, P.; Singh, A.K.; Sonawane, V.C.; Bharagava, R.N.; Raj, A. Decolourisation of Textile Dye by Laccase: Process Evaluation and Assessment of Its Degradation Bioproducts. Bioresour. Technol. 2021, 340, 125591. [Google Scholar] [CrossRef]
- Savoie, J.M.; Mata, G.; Mamoun, M. Variability in Brown Line Formation and Extracellular Laccase Production during Interaction between White-Rot Basidiomycetes and Trichoderma harzianum Biotype Th2. Mycologia 2001, 93, 243–248. [Google Scholar] [CrossRef]
- Hailei, W.; Guangli, Y.; Ping, L.; Yanchang, G.; Jun, L.; Guosheng, L.; Jianming, Y. Overproduction of Trametes Versicolor Laccase by Making Glucose Starvation Using Yeast. Enzym. Microb. Technol. 2009, 45, 146–149. [Google Scholar] [CrossRef]
- Wang, F.; Hu, J.-H.; Guo, C.; Liu, C.-Z. Enhanced Laccase Production by Trametes Versicolor Using Corn Steep Liquor as Both Nitrogen Source and Inducer. Bioresour. Technol. 2014, 166, 602–605. [Google Scholar] [CrossRef]
- Sperandio, G.B.; Ferreira Filho, E.X. Fungal Co-Cultures in the Lignocellulosic Biorefinery Context: A Review. Int. Biodeterior. Biodegrad. 2019, 142, 109–123. [Google Scholar] [CrossRef]
- Pi, H.-W.; Anandharaj, M.; Kao, Y.-Y.; Lin, Y.-J.; Chang, J.-J.; Li, W.-H. Engineering the Oleaginous Red Yeast Rhodotorula glutinis for Simultaneous β-Carotene and Cellulase Production. Sci. Rep. 2018, 8, 10850. [Google Scholar] [CrossRef] [PubMed]
- Li, J.; Chen, Y.; Gao, A.; Wei, L.; Wei, D.; Wang, W. Simultaneous Production of Cellulase and β-Carotene in the Filamentous Fungus Trichoderma reesei. J. Agric. Food Chem. 2023, 71, 6358–6365. [Google Scholar] [CrossRef] [PubMed]
- Li, N.; Zeng, Y.; Chen, Y.; Shen, Y.; Wang, W. Induction of Cellulase Production by Sr2+ in Trichoderma reesei via Calcium Signaling Transduction. Bioresour. Bioprocess. 2022, 9, 96. [Google Scholar] [CrossRef]
- Roth, S.; Spiess, A.C. Laccases for Biorefinery Applications: A Critical Review on Challenges and Perspectives. Bioprocess Biosyst. Eng. 2015, 38, 2285–2313. [Google Scholar] [CrossRef]
- Matei, J.C.; Soares, M.; Bonato, A.C.H.; de Freitas, M.P.A.; Helm, C.V.; Maroldi, W.V.; Magalhães, W.L.E.; Haminiuk, C.W.I.; Maciel, G.M. Enzymatic Delignification of Sugar Cane Bagasse and Rice Husks and Its Effect in Saccharification. Renew. Energy 2020, 157, 987–997. [Google Scholar] [CrossRef]
- Peláez, R.D.R.; Wischral, D.; Mendes, T.D.; Pacheco, T.F.; Urben, A.F.; Helm, C.V.; Mendonça, S.; Balan, V.; de Siqueira, F.G. Co-Culturing of Micro- and Macro-Fungi for Producing Highly Active Enzyme Cocktail for Producing Biofuels. Bioresour. Technol. Rep. 2021, 16, 100833. [Google Scholar] [CrossRef]
- Yusuf, M. Synthetic Dyes: A Threat to the Environment and Water Ecosystem. In Textiles and Clothing; Wiley Online Books; Scrivener Publishing LLC.: Beverly, MA, USA, 2019; pp. 11–26. [Google Scholar]
- Benkhaya, S.; M’ rabet, S.; El Harfi, A. A Review on Classifications, Recent Synthesis and Applications of Textile Dyes. Inorg. Chem. Commun. 2020, 115, 107891. [Google Scholar] [CrossRef]
- Hofrichter, M.; Ullrich, R.; Pecyna, M.J.; Liers, C.; Lundell, T. New and Classic Families of Secreted Fungal Heme Peroxidases. Appl. Microbiol. Biotechnol. 2010, 87, 871–897. [Google Scholar] [CrossRef] [PubMed]
- Afiya, H.; Ahmet, E.E.; Shah, M.M. Enzymatic Decolorization of Remazol Brilliant Blue Royal (RB 19) Textile Dye by White Rot Fungi. J. Appl. Adv. Res. 2019, 4, 11–15. [Google Scholar] [CrossRef]
- Tavares, M.F.; Avelino, K.V.; Araújo, N.L.; Marim, R.A.; Linde, G.A.; Colauto, N.B.; do Valle, J.S. Decolorization of Azo and Anthraquinone Dyes by Crude Laccase Produced by Lentinus Crinitus in Solid State Cultivation. Braz. J. Microbiol. 2020, 51, 99–106. [Google Scholar] [CrossRef] [PubMed]
- Forootanfar, H.; Moezzi, A.; Aghaie-Khozani, M.; Mahmoudjanlou, Y.; Ameri, A.; Niknejad, F.; Faramarzi, M.A. Synthetic Dye Decolorization by Three Sources of Fungal Laccase. Iran. J. Environ. Health Sci. Eng. 2012, 9, 27. [Google Scholar] [CrossRef]
- Cardoso, B.K.; Linde, G.A.; Colauto, N.B.; do Valle, J.S. Panus Strigellus Laccase Decolorizes Anthraquinone, Azo, and Triphenylmethane Dyes. Biocatal. Agric. Biotechnol. 2018, 16, 558–563. [Google Scholar] [CrossRef]
- Glazunova, O.A.; Trushkin, N.A.; Moiseenko, K.V.; Filimonov, I.S.; Fedorova, T. V Catalytic Efficiency of Basidiomycete Laccases: Redox Potential versus Substrate-Binding Pocket Structure. Catalysts 2018, 8, 152. [Google Scholar] [CrossRef]
- Kachlishvili, E.; Asatiani, M.; Kobakhidze, A.; Elisashvili, V. Trinitrotoluene and Mandarin Peels Selectively Affect Lignin-Modifying Enzyme Production in White-Rot Basidiomycetes. SpringerPlus 2016, 5, 252. [Google Scholar] [CrossRef]
- Salvachúa, D.; Martínez, A.T.; Tien, M.; López-Lucendo, M.F.; García, F.; De Los Ríos, V.; Martínez, M.J.; Prieto, A. Differential Proteomic Analysis of the Secretome of Irpex lacteus and Other White-Rot Fungi during Wheat Straw Pretreatment. Biotechnol. Biofuels 2013, 6, 115. [Google Scholar] [CrossRef]

Disclaimer/Publisher’s Note: The statements, opinions and data contained in all publications are solely those of the individual author(s) and contributor(s) and not of MDPI and/or the editor(s). MDPI and/or the editor(s) disclaim responsibility for any injury to people or property resulting from any ideas, methods, instructions or products referred to in the content. |
© 2023 by the authors. Licensee MDPI, Basel, Switzerland. This article is an open access article distributed under the terms and conditions of the Creative Commons Attribution (CC BY) license (https://creativecommons.org/licenses/by/4.0/).
Share and Cite
Peláez, R.D.R.; Serra, L.A.; Wischral, D.; Cunha, J.R.B.; Mendes, T.D.; Pacheco, T.F.; de Siqueira, F.G.; de Almeida, J.R.M. Improvement of Laccase Activity in Co-Culture of Panus lecomtei and Sporidiobolus pararoseus and Its Application as an Enzymatic Additive in Biomass Hydrolysis and Dye Decolorization. Fermentation 2023, 9, 945. https://doi.org/10.3390/fermentation9110945
Peláez RDR, Serra LA, Wischral D, Cunha JRB, Mendes TD, Pacheco TF, de Siqueira FG, de Almeida JRM. Improvement of Laccase Activity in Co-Culture of Panus lecomtei and Sporidiobolus pararoseus and Its Application as an Enzymatic Additive in Biomass Hydrolysis and Dye Decolorization. Fermentation. 2023; 9(11):945. https://doi.org/10.3390/fermentation9110945
Chicago/Turabian StylePeláez, Rubén Darío Romero, Luana Assis Serra, Daiana Wischral, Joice Raísa Barbosa Cunha, Thais Demarchi Mendes, Thályta Fraga Pacheco, Felix Gonçalves de Siqueira, and João Ricardo Moreira de Almeida. 2023. "Improvement of Laccase Activity in Co-Culture of Panus lecomtei and Sporidiobolus pararoseus and Its Application as an Enzymatic Additive in Biomass Hydrolysis and Dye Decolorization" Fermentation 9, no. 11: 945. https://doi.org/10.3390/fermentation9110945
APA StylePeláez, R. D. R., Serra, L. A., Wischral, D., Cunha, J. R. B., Mendes, T. D., Pacheco, T. F., de Siqueira, F. G., & de Almeida, J. R. M. (2023). Improvement of Laccase Activity in Co-Culture of Panus lecomtei and Sporidiobolus pararoseus and Its Application as an Enzymatic Additive in Biomass Hydrolysis and Dye Decolorization. Fermentation, 9(11), 945. https://doi.org/10.3390/fermentation9110945

